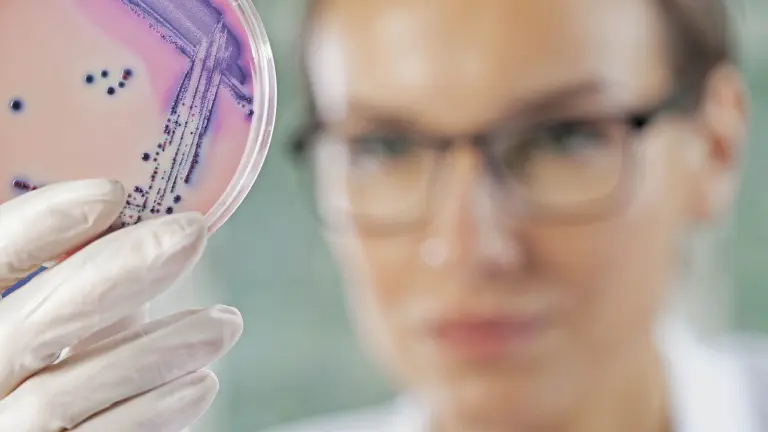
main image

Lectura 4:00 min
Breve historia de las bacterias. De monstruos...
Desde antes de formar parte de la especie que hoy somos, los Homo sapiens nos hemos enfrentado a monstruos, toda la vida, todos los días de nuestra vida. Estos monstruos son pequeños, microscópicos en realidad, pero son los organismos que más vidas humanas han cobrado a lo largo de la Historia. Hasta finales del XVII, cuando el neerlandés Anton van Leeuwenhoek descubrió sus animáculos, los primeros seres unicelulares, y empezamos a pensar en ellos como organismos patógenos, los humanos creíamos que las enfermedades eran transmitidas por un “miasma” una especie de efluvio maléfico que nos hacía enfermar, y éramos tan ignorantes como impotentes ante sus ataques; cualquier corte, por pequeño que fuera, nos podía matar.
Menos de un siglo después el microbiólogo alemán Robert Koch identificaba por primera vez distintos organismos como patógenos como el bacilo del carbunco, una enfermedad bacteriana que afectaba mayormente a las vacas (y a humanos también, desde luego, después de todo es el origen del ántrax) y el bacilo causante de la tuberculosis, la “plaga blanca” que diezmó la población de Inglaterra a lo largo de un siglo y cuyo causante lleva el nombre de su descubridor. Y a principios del siglo XX, a finales de la primera Gran Guerra, el escocés Alexander Fleming descubrió un hongo cuyas esporas aterrizaron por accidente en una de las cajas de Petri donde cultivaba muestras de estafilococos. En todas las colonias que se formaron alrededor del hongo, las bacterias todas se habían vuelto transparentes, como si se hubieran disuelto.
Este hallazgo dio origen a uno de los más grandes y más relevantes descubrimientos en la historia de la medicina y la ciencia en general: los primeros antibióticos. Penicillium notatum, el hongo que descubrió Fleming produce una sustancia que interactúa con la pared celular de las bacterias y las disuelve, pero sin afectar las células humanas (que no tienen pared celular, sino una membrana mucho más compleja). A partir de la penicilina se fue ampliando nuestro conocimiento de los antibióticos y empezamos a descubrir más y más tipos de ellos, todo un arsenal de armas cada vez más específicas y letales para usar en nuestra lucha contra los pequeños monstruos.
Pero somos humanos. Las empresas que desarrollaron estos medicamentos querían amortizar sus inversiones y obtener beneficios por ellas. Así, los doctores nos fueron recetando cada vez más antibióticos ante el primer síntoma de una infección. Pero los monstruos, a pesar de no ser humanos, también evolucionan y lo hacen mucho más rápido que nosotros. Con cada nueva generación (y pueden ser cientos o en un día) surgen nuevas mutaciones, y eventualmente una joven bacteria nace resistente a un antibiótico. Además, las bacterias tienen otra manera de intercambiar material genético mediante el intercambio de plásmidos que circulan en su interior, y esto las ayuda a desarrollar resistencia a más tipos de antibióticos, que luego heredan las nuevas generaciones.
Esto ha dado como resultado nuevas cepas de organismos superresistentes a la mayoría de los antibióticos conocidos: las superbacterias; y ya hemos ubicado distintas especies en hospitales de todo el mundo, verdaderos caldos de cultivo para este tipo de monstruos. Incluso muchos científicos, quizá los más fatalistas, piensan que estamos ante el colapso de la medicina como la conocemos. Sin antibióticos efectivos nos veremos nuevamente en una época oscura, donde una muela picada, o el simple corte con un alambre oxidado resultaría mortal por necesidad. A pesar de esto, seguimos tomando antibióticos al primer síntoma de resfriado, aunque los antibióticos ni siquiera son efectivos contra los virus.
El ser humano es de memoria corta, muy corta. Primero le perdimos miedo a los monstruos que nos mataban y después a las armas que usábamos para destruirlos. Los antibióticos deben ser un último recurso en nuestra lucha contra las infecciones, no la primera opción, y siempre deben ser tomados como un tratamiento completo y no como si fueran aspirinas para calmar un molesto resfriado. Y los antibióticos que ingerimos de manera consciente no son nuestro único problema: estamos creando superbacterias en el interior de nuestros cuerpos, en los océanos, y hasta en la carne de la hamburguesa de primera que he comido hoy más temprano.

